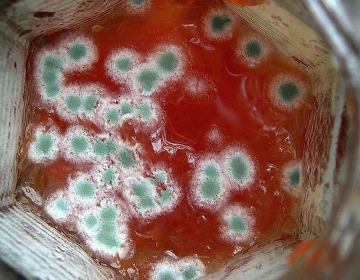

2024. 6. 15. 21:28ㆍ카테고리 없음

식중독 예방 원칙
복통과 설사 구토 등의 대표적인 증상으로 나타나는 식중독 예방 할 수 있는 방법을 소개합니다. 특히 여름에 더 많이 주의해야 하지만 사실은 1년 내도록 항상 외식을 하거나 집에서의 식사에서도 조심해야 합니다.
식중독 원인은 세균과 바이러스입니다. 습도와 온도 조건만 갖춰지면 음식 안에서 증식하고 우리가 그 음식을 먹게 되어 걸리게 됩니다. 또 다른 원인인 바이러스는 음식안에서 증식하는 것은 아니지만 음식을 매개로 몸 안으로 들어와 사람의 내장기관에서 증식하면서 식중독 일으키게 됩니다. 그리고 온도가 낮거나 건조하면 더 오래 살아남습니다.
6~8월 여름에는 장출혈성 대장균, 캄필로박터, 살모넬라 등 세균이 원인이 되는 식중독 많습니다. 11월~3월 겨울철에 많이 발생하는 것은 노로바이러스 등이 원인인 경우가 많습니다. 이 외에도 자연독, 기생충 등이 원인이기도 합니다.

식중독 걸리지 않도록 주의해야 하는 기본은 이러한 원인이 되는 세균이나 바이러스를 막을 수 있는 방법은 세균이나 바이러스가 음식물에 생기지 않게, 증식하지 않게 그리고 물리치는 이 3가지 지켜야 합니다.
식중독 원인균이 음식에 생기지 않게 하기 위한 첫번째는 잘 씻는 것입니다. 조리 시작 전후, 애기 기저귀를 만지거나 반려동물 등을 만진 후, 식탁에 앉기 전, 남은 음식 정리하기 전에는 반드시 손을 씻어야 합니다. 생고기나 생선 다룬 도마나 칼은 잘 세척하고 가능하면 살균합니다.
식중독 원인균이 증식하지 않도록 하기 위해서는 저온에 보관하는 것입니다. 세균은 고온다습한 환경에서 활발하게 증식하고 영하 15도 이하가 되면 증식을 멈춥니다. 냉동 시킬 수 있는 것은 냉동 시키는 것이 두번째 예방 방법입니다.
세번째는 대부분의 세균과 바이러스는 가열을 하면 죽는다는 점을 이용합니다. 고기나 생선은 물론 채소류도 가능하면 가열해서 섭취하면 식중독 걸릴 확률이 낮아집니다. 그리고 조리기구 등도 뜨거운 물로 세척하고 살균 과정을 거칩니다.





위의 예방 방법은 세균 관련한 내용이었다면 이제 아래에는 또 하나의 원인인 바이러스 관련한 내용입니다.
첫번째는 원인 바이러스에 감염되지 않도록, 만약 감염되었다면 음식을 만드는 일에 관여하면 안됩니다. 가장 간단하게 예를 들자면 감기도 바이러스이므로 감기 걸렸다면 음식조리를 하지말고 푹 쉬어야 합니다. 그리고 식중독 바이러스에 감염되었을 수도 있으니 주의해야 합니다.
두번째로는 손을 잘 씻는 것입니다. 그리고 정기적인 소독과 청소입니다. 그리고 세번째는 세균때와 마찬가지로 조리기구의 소독과 살균입니다.
즉 식중독 원인이 되는 것이 세균이든 바이러스든 상관없습니다. 기본적으로는 건강관리와 손을 잘 씻는 것 그리고 조리기구의 살균 및 음식물을 가열해서 섭취하는 것입니다. 잊지마세요. 이것이 바로 예방 3가지 원칙입니다.